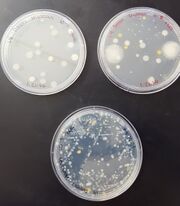

Uploads by Cara Chao
From OpenWetWare
Jump to navigationJump to search
This special page shows all uploaded files.
| Date | Name | Thumbnail | Size | Description |
|---|---|---|---|---|
| 05:04, 1 March 2016 | Green Colonie Results.jpg (file) |  |
194 KB | |
| 05:04, 1 March 2016 | Tan Colonie Results.jpg (file) |  |
314 KB | |
| 22:32, 24 February 2016 | 20160224 173039.jpg (file) |  |
83 KB | |
| 21:51, 24 February 2016 | Transect 4 Vertebrate Data Table.jpg (file) |  |
112 KB | |
| 21:37, 24 February 2016 | Transect 4 Vertebrates pic.jpg (file) |  |
1.28 MB | |
| 20:12, 17 February 2016 | PlantCharacterizationTableHCD.jpg (file) |  |
188 KB | |
| 20:02, 10 February 2016 | 16S rRNA Gel Run HDC.jpg (file) |  |
159 KB | |
| 06:00, 10 February 2016 | Colony data table.jpg (file) |  |
95 KB | |
| 22:42, 9 February 2016 | Quantifying & observing microorganisms.jpg (file) |  |
64 KB | |
| 03:42, 4 February 2016 | 20160128 150928.jpg (file) |  |
399 KB | |
| 03:08, 4 February 2016 | 20160128 155335.jpg (file) | |
437 KB | |
| 02:53, 4 February 2016 | 20160202 233539.jpg (file) |  |
493 KB | |
| 22:56, 2 February 2016 | 20160120 130650.jpg (file) |  |
418 KB | |
| 22:15, 2 February 2016 | 2016-01-20 12.48.21.jpg (file) |  |
556 KB | |
| 22:12, 2 February 2016 | 2016-01-20 12.46.33.jpg (file) |  |
306 KB | |
| 02:53, 26 January 2016 | 20160120 132918.jpg (file) |  |
160 KB | |
| 02:51, 26 January 2016 | 20160120 123422.jpg (file) |  |
420 KB | |
| 02:39, 26 January 2016 | 20160120 123744.jpg (file) |  |
371 KB | |
| 02:14, 17 January 2016 | Chao Transect 3.jpg (file) |  |
117 KB | |
| 02:09, 17 January 2016 | Transect 3 photo.jpg (file) |  |
117 KB |